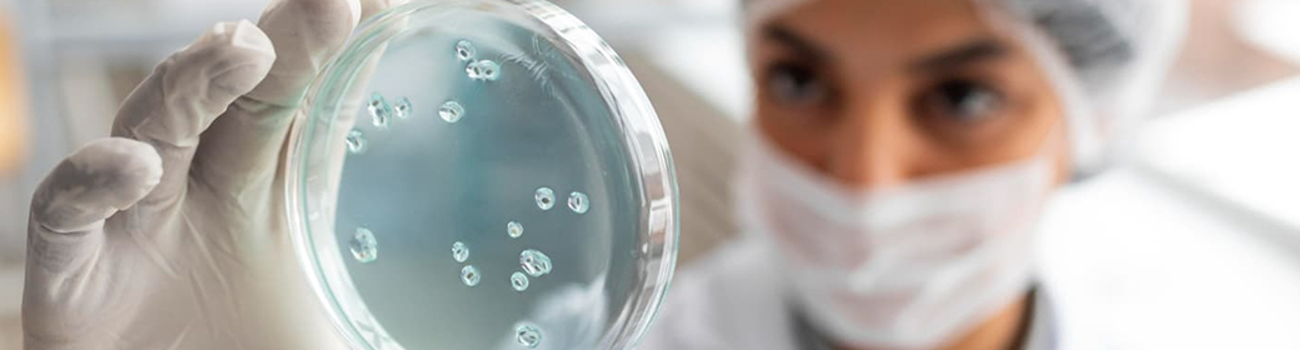
Catalent Detail Banner

Travailler chez Novo Nordisk Production Belgium
Novo Nordisk est une entreprise mondiale de soins de santé, fondée en 1923 et dont le siège social est situé juste à l’extérieur de Copenhague, au Danemark.
Notre objectif est de provoquer des changements pour vaincre le diabète et d’autres maladies chroniques graves telles que l’obésité, les maladies sanguines et endocriniennes rares.
Pour ce faire, nous faisons œuvre de pionnier en réalisant des percées scientifiques, en élargissant l'accès à nos médicaments et en nous efforçant de prévenir et, à terme, de guérir les maladies que nous traitons.
Nous employons plus de 77 000 personnes dans 80 bureaux à travers le monde et commercialisons nos produits dans 170 pays.




Offres d'emploi chez Novo Nordisk
Nous avons trouvé offres d'emploi offre d'emploi pour vous.